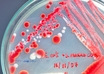

Mental distress may increase CVD risk in older adults
IANS | Aug 30, 2018
Over 80% of UTIs caused by E.coli found in poultry: Study
IANS | Aug 30, 2018
Anaemia drug could help recovery after a heart attack: JACC Study
IANS | Aug 30, 2018
Chemotherapy may cause early menopause risk in women: Study
IANS | Aug 30, 2018
Jury still out on aspirin a day to prevent heart attack and stroke
ESC 2018 Press Release | Aug 30, 2018
Anaemia in pregnancy may signal heart disease, says study
IANS | Aug 29, 2018
Inadequate sleep may fuel cardiovascular diseases in men: ESC Congress 2018
ANI | Aug 29, 2018
Consumption of dairy products may prevent cerebrovascular diseases
IANS | Aug 29, 2018
NASA working for better cancer treatments in space: Report
IANS | Aug 29, 2018
Removable balloon as good as permanent stent implant for arteries: The Lancet
ESC 2018 Press Release | Aug 29, 2018
Most read this week